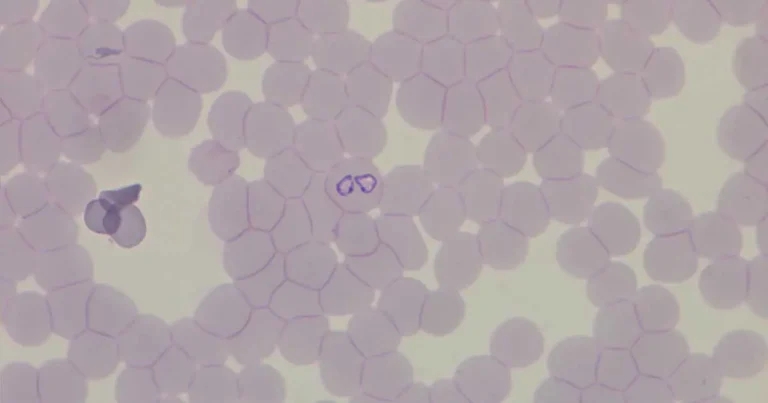
Disease, diagnostics and travel

10 Mar 2026
Sandra Wells BSc(Hons) covers some of the most common diseases and their vectors picked up by pets, from abroad and in the UK, and how to screen for them.
Figure 1. Intra-erythrocytic Babesia canis in a dog.
Pet travel is not new, but in recent years the patterns and consequences of that movement have changed.
Before the Pet Travel Scheme, only a small minority of UK pets ever left the country. The introduction of pet passports has led to an increase in pet travel and, despite post-Brexit changes, many owners still choose to take their pet abroad.
At the same time, the importation of dogs from countries where vector-borne diseases are endemic continues at scale. In 2024, five per cent of dogs owned for one year or less were acquired from abroad, equating to around 82,000 dogs imported for pet ownership in a 12-month period1.
Add to this the effects of accelerating climate change. Warmer, wetter seasons have extended vector activity across Europe and the UK, and together these trends mean we are now encountering vector-borne diseases (Panel 1) that were once confined to more distant shores.
Whether screening an imported dog, investigating non-specific illness in a recently travelled animal, or exploring unusual clinical signs, laboratory diagnostics play a central role in vector-borne disease prevention, surveillance and control.

Vector-borne diseases are caused by a wide range of infectious agents, including viruses, bacteria, protozoa and helminths. Key vectors include ticks, mosquitoes and flies2.
Globally, ticks are responsible for the majority of vector-borne disease transmission – around 95 per cent of cases in one study – and their geographic range is continuing to expand3. For UK travelling pets, tick-borne pathogens are one of the principal concerns, alongside important non tick-borne infections such as Dirofilaria immitis (heartworm), transmitted by mosquitoes, and Leishmania infantum, transmitted by sandflies4,5. Emerging or less familiar vector-borne pathogens include Thelazia callipaeda (the eyeworm), transmitted by Phortica variegata (a fruit fly of the Drosophilidae family).
Imported dogs add further complexity. Many arrive from southern and eastern Europe, where exposure to Babesia canis, Ehrlichia canis, Anaplasma platys, Hepatozoon canis and Borrelia burgdorferi is commonplace.
Some of these pathogens can establish carrier states, with animals appearing clinically normal on arrival but capable of developing clinical disease weeks or months later.
This highlights the importance of a thorough travel and importation history.
Clinicians are, therefore, encountering pathogens once considered rare or “exotic.” Some, such as Leishmania infantum, are unlikely to establish in the UK due to the absence of sandfly vectors. Others – particularly tick-associated and mosquito-associated pathogens – are far more adaptable.
Even without considering more exotic tick species, the UK is already home to at least 20 native tick species6, with Ixodes ricinus (commonly known as the sheep or deer tick) being the most widespread and relevant to veterinary and public health (Table 1).

Tick-borne diseases are challenging to diagnose based on clinical signs alone – especially as infections may be subclinical. When clinical disease is present, signs can range from mild and non-specific – such as lethargy, pyrexia and lymphadenopathy – to severe and life threatening. Babesiosis, for example, may result in icterus due to intravascular haemolysis, with potential complications including prolonged bleeding, petechiae or ecchymoses, and neurological signs. A thorough diagnostic work-up, including routine biochemistry and haematology (Panel 2), is essential to identify the underlying cause and guide treatment.

In some cases, patient-side point-of-care tests will be the next diagnostic step. In-house assays are readily available and can provide useful initial information.
However, most patient-side tests for vector-borne disease detect antibodies rather than the pathogen itself. As a result, they primarily indicate prior exposure rather than active infection. Test timing is also critical. In the early stages of infection, dogs may test negative due to the lag between exposure and seroconversion, which can extend to three weeks or more7. Where results are equivocal, unexpected or inconsistent with the clinical picture, further investigation is warranted.
Quantitative PCR testing is an essential tool in the investigation of suspected vector-borne disease – particularly in dogs that have travelled abroad or been imported from endemic regions. Unlike serology, which reflects an immune response to exposure, PCR detects pathogen DNA and confirms active infection at the time of sampling.
Quantitative PCR assays are highly sensitive and specific, and when used early in the disease course can detect infection before an antibody response occurs. Many veterinary laboratories offer pathogen-specific or multiple tick-borne disease (multiplex) panels, allowing simultaneous testing for Babesia, Ehrlichia, Anaplasma and Hepatozoon species from a single EDTA blood sample – an approach that is particularly helpful when investigating dogs with vague signs or complex travel histories.
As with all diagnostic tools, PCR results must be interpreted in context. A positive result provides strong evidence of active infection, while a negative result does not always exclude disease – particularly if sampling occurs very early or if the pathogen is localised within tissues rather than circulating in peripheral blood. In such cases, repeat testing, alternative sample types or discussion with the diagnostic laboratory may be required.
While diagnostic principles are broadly similar for most vector-borne infections, individual pathogens present distinct challenges related to factors including tissue distribution and timing of diagnostic testing.
Understanding these differences helps clinicians select appropriate tests and interpret results accurately.
Babesiosis is one of the most clinically significant tick-borne diseases in the UK – particularly following the establishment of Babesia canis in localised areas. Although Babesia-infected ticks are encountered less frequently than those carrying Borrelia species, regional clusters of increased risk have been identified8,9.
Several Babesia species can infect dogs, including B canis, B vogeli, B rossi, B gibsoni and B vulpes4,8,9. B canis is currently the most clinically significant pathogenic species in Europe.
Diagnosis is traditionally based on clinical presentation alongside identification of intra-erythrocytic parasites on blood smear examination (Figures 1 and 2). Detection is most successful in acute infection – particularly when capillary blood smears are examined, as trophozoites and merozoites are more readily identified than in venous samples. The ear pinna offers a practical site for capillary sampling in suspected cases.
However, parasite numbers may be low or intermittent in chronic infection, in partially treated dogs, or in cases involving less virulent species such as B canis canis or B canis vogeli. In these situations, microscopy may fail to detect infection.
Quantitative PCR testing on EDTA blood provides significantly greater sensitivity and specificity, and is recommended where clinical suspicion persists despite negative smear findings.

Other tick-borne infections that are becoming increasingly important – particularly in those pets travelling in or from southern and eastern Europe – include Ehrlichia canis (Figure 3) and Anaplasma species (Figure 4).

Thrombocytopenia is a common laboratory finding with E canis, although it is not disease specific. Microscopic examination of blood smears may reveal morulae in lymphocytes and/or monocytes, but sensitivity is relatively low10.
Serology is highly sensitive for detecting exposure, with seroconversion typically occurring one to four weeks after infection. Quantitative serology can be used if active infection is suspected, with a four-fold increase in titres taken two weeks apart being confirmatory.
PCR testing can be used to confirm active infection. However, circulating organism levels may be low or intermittent – particularly in chronic infection – reducing the sensitivity of blood-based PCR.
In these cases, PCR testing of bone marrow or splenic aspirates may improve diagnostic sensitivity, reflecting localisation of organisms within reticuloendothelial tissues rather than peripheral circulation. This approach is useful where clinical suspicion remains high despite a negative blood PCR result.

Infection with Hepatozoon canis is increasingly recognised in dogs imported from southern and eastern Europe. Unlike most tick-borne infections, transmission occurs through ingestion of an infected tick rather than via a bite.
This is not the only way in which H canis differs from other tick-borne infections, as blood smear examination carries a high sensitivity and specificity.
PCR testing increases that accuracy still further9.
Tick-borne pathogens do not always occur in isolation. In dogs – especially those imported from endemic areas – co-infections with Babesia, Ehrlichia and Anaplasma species are common, and can significantly influence both clinical presentation and response to treatment.
Immunosuppression from one pathogen may exacerbate disease caused by another, and overlapping signs can complicate diagnosis.
This underscores the value of comprehensive screening using multiplex quantitative PCR panels, which allows simultaneous detection of multiple vector-borne pathogens from a single blood sample.
Although Lyme disease (Borrelia burgdorferi) is endemic in the UK and not specific to travelling pets, no discussion of vector-borne disease is complete without mention of this diagnostically complex infection.
Many seropositive dogs remain clinically normal, while some dogs may develop clinical signs before seroconversion, meaning early serology can be negative.
PCR testing can provide supportive evidence, but it has limited sensitivity when performed on peripheral blood, as organisms tend to localise within tissues.
In dogs with joint involvement, PCR testing of synovial fluid may be more informative.
As with other vector-borne infections, results should always be interpreted in the context of clinical findings and exposure risk.
Unlike the tick-borne infections discussed, Leishmania infantum is transmitted by sandflies and is an important consideration in dogs that have travelled to, or been imported from, endemic regions.
Although autochthonous transmission is unlikely in the UK due to the absence of competent vectors, infection may remain subclinical for months or years before clinical disease becomes apparent. A detailed discussion of diagnosis is beyond the scope of this article.
Serology is widely used for screening and monitoring exposure. PCR testing significantly improves diagnostic sensitivity – particularly when performed on lymph node aspirates (Figure 5), bone marrow or conjunctival swabs, reflecting the tissue localisation of the parasite. Leishmaniosis should remain on the differential list for any dog with compatible clinical signs and a relevant travel history.

Tick-borne pathogens account for the majority of vector-borne infections encountered in travelling pets, but they are not the only diseases of concern.
Mosquito-borne infections such as Dirofilaria immitis remain highly relevant in dogs travelling to, or imported from, endemic regions. Diagnosis typically centres on detection of circulating adult female antigens, often supported by assessment for microfilariae using blood-film examination (Figure 6) or concentration techniques such as the modified Knott’s test.
Interpretation of results requires careful consideration of timing, prior prophylaxis and infection burden, as antigen tests may be negative in early infection or in dogs with low worm numbers.
A less commonly encountered infection, the eyeworm Thelazia callipaeda, is transmitted by flies an

d is increasingly recognised in dogs returning from parts of mainland Europe. In contrast to most vector-borne infections, diagnosis of Thelazia callipaeda is usually clinical, based on direct visual identification of adult worms within the conjunctival sac or beneath the eyelids, with laboratory confirmation rarely required.
Other travel-associated parasitic risks, such as Linguatula serrata (Panel 3), are not vector borne, but may be encountered in imported dogs.

With increasing pet travel, large-scale importation of dogs and an expanding UK vector landscape, vector-borne disease should now be considered part of everyday differential diagnosis. Clinical signs are often non-specific, and infections may remain subclinical for prolonged periods, making diagnosis challenging without appropriate laboratory support.
A thorough travel history, awareness of regional risks and strategic use of diagnostic testing are essential. By understanding the strengths and limitations of available tests, clinicians can improve diagnostic accuracy, guide appropriate treatment and contribute to ongoing disease surveillance.
Sandra Wells holds a BSc(Hons) in Applied Biology with Biochemistry from Coventry University and a postgraduate qualification in Molecular Biology from Lancaster University. Throughout her career, she has held senior roles including head of biochemistry, laboratory manager and group quality manager. At NationWide Laboratories, Sandra oversees operations across all sites, strengthening service quality and advancing diagnostic capability to ensure the organisation remains equipped to meet evolving veterinary challenges, from emerging vector‑borne diseases to the increasing complexity of modern clinical diagnostics.